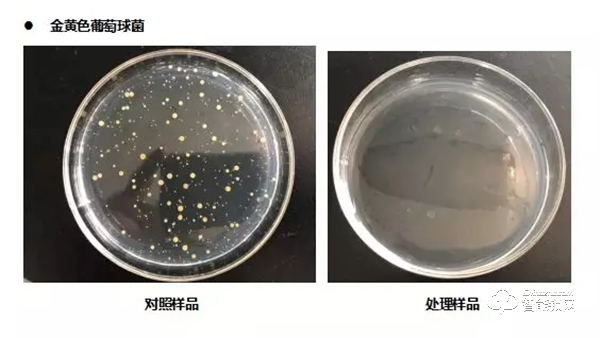
雅潔五金抗菌黑科技，從細微處呵護家人健康

當前位置:
門鎖網>
門鎖新聞>
品牌資訊>
詳情
手機版最新留言:
使用手機微信“掃一掃”功能,掃描以下二維碼,即可將本文分享到“朋友圈”中。
2021-08-16 編輯:中國門鎖網 來源:網絡 瀏覽數:6345
最近新冠肺炎病毒肆意橫行,為了家人的健康,我們需要做到:多通風、勤洗手、用消毒水清潔家居物件,最值得注意的是出入戴口罩、不去人多的地方。據報道說此次疫情中家庭聚集性傳播占比大,此外廣州確診患者家中門把...
最近新冠肺炎病毒肆意橫行,為了家人的健康,我們需要做到:多通風、勤洗手、用消毒水清潔家居物件,最值得注意的是出入戴口罩、不去人多的地方。
據報道說此次疫情中家庭聚集性傳播占比大,此外廣州確診患者家中門把手上發現新冠病毒蹤跡,家居健康引發了我們的高度關注。大家有沒有那么一刻下決心日后要加倍地關愛家人呢?
關愛家人健康,必須從細節做起。居家生活中,門鎖是我們每天必須會觸碰到的。進出家門容易攜帶外來細菌,廚房的油煙、衛生間的潮濕都容易滋生細菌,這些地方的門把手常常會因為使用頻率高導致很難被徹底且及時地清潔。
雅潔智慧黑科技抗菌五金應運而生,作為家居健康五金的前行者,雅潔一直倡導極智呵護家人的健康,讓幸福生活相伴左右,雅潔的抗菌五金產品涵蓋有:抗菌智能門鎖、抗菌機械門鎖、抗菌家具五金、抗菌門用五金、抗菌衛浴五金等。
01 雅潔門鎖抗菌的原理是什么?
雅潔抗菌門鎖涂有銀離子抗菌涂層,具有抑制微生物的生長、繁殖或殺死微生物的作用,具體表現為:
1、銀離子能穿透附著的微生物,對細菌細胞壁起干擾作用;
2、銀離子能破壞微生物的DNA,阻止它們不斷復制增生,直至完全死亡;
3、銀離子在殺菌的同時,不會損傷正常的細胞。

銀離子可以抑制和殺死650多種微生物,對大腸桿菌、金黃色葡萄球菌、白色念珠菌等的抑制和滅殺更是效果顯著。
02 雅潔門鎖抗菌的作用是什么?
雅潔抗菌門鎖是經過廣東省微生物分析檢測中心檢測的,在試驗室測試條件下,對大腸桿菌、金黃色葡萄球菌的抗菌率高達99%。雅潔抗菌技術抗菌率高達99%,高于GB\T21866-2008標準的I級標準,讓家居健康的“細菌防護”有多一層可靠的保證。

此外,第三方檢驗機構根據《消毒技術規范》2002年版和GB/T 16886.12-2005《醫療器械生物學評價》兩份文件,進行相關檢測,檢測項目是一次完整皮膚刺激性/腐蝕性試驗。在試驗條件下,抗菌產品對新西蘭兔一次完成皮膚刺激性/腐蝕性實驗結果為無刺激性。因此,一般情況下雅潔抗菌產品對皮膚無刺激作用。
03 雅潔門鎖抗菌時長是多久?
雅潔抗菌涂層的產品在抗菌性能、抗菌耐久性上表現卓越,抗菌涂層的活性是持久的,原則上是涂層不被損毀,抗菌性能一直都在。
抗菌性能及抗菌耐久性試驗是根據GB/T 21866-2008 抗菌涂料(漆膜)抗菌性測定法和抗菌效果標準中抗菌耐久性試驗;試驗條件下,使用1支30W,波長253.7nm的紫外燈,抗菌產品距離紫外燈0.8m~1.0m,照射100h處理后,再進行抗菌性能檢驗,對大腸桿菌和金黃色葡萄球菌的抗菌率還能維持在99%以上。
經廣東省微生物分析檢測中心提供的抗菌檢測報告,在試驗室測試條件下,雅潔抗菌產品的抗菌耐久性維持在99%以上,遠遠超過國家標準95%以上的Ⅰ級要求。
以下是大腸桿菌和金黃色葡萄球菌檢測結果對照。

04 雅潔抗菌門鎖好物清單
家不僅僅是一所房子,里面有著我們與家人間最為醇厚的愛意以及對美好生活的向往。一個有溫度有健康的家往往是從我們追求細節的美開始,從家里的每個細節開始,亦從家的“門面”——抗菌門鎖開始。雅潔抗菌門鎖致力于為你締造健康好生活。
入戶門小雅推薦抗菌智能門鎖,智能與安全科技的完美融合,除了擁有時尚的外觀外,還讓讓家變得智慧又安全。



雅潔抗菌技術至今已是一種很成熟的技術,除了擁有實力抗菌性能外,還擁有時尚的外觀和多選擇性色彩。雅潔抗菌解決方案不僅適用于家庭,同時還適用于醫院、療養院、幼兒園、學校、餐廳、酒店等對衛生安全要求高的公共場所。
雖然疫情當前,但沒有哪個冬天不可逾越,沒有哪個春天不會來臨。讓我們時刻關愛,預防先行,用抗菌門鎖為家做一道科學防護吧。
*意向地區:
*您的姓名:
*聯系電話:
需求說明:
想了解這個項目,請聯系我!
我想加盟,請將項目的資料發給我。
請問我所在地區有加盟商了嗎?
想了解此項目的加盟流程,請聯系我!
請問加盟此項目需投資多少錢?
版權與免責聲明:
凡未注明稿件來源的內容均為轉稿或由企業用戶注冊發布,本網轉載出于傳遞更多信息的目的,如轉稿涉及版權問題,請作者聯系我們處理。我們對頁面中展示內容的真實性、準確性和合法性均不承擔任何法律責任。
如內容信息對您產生影響,請及時聯系我們修改或刪除。
13520832007

2025北京木門展,中國木門網采訪洛克曼智能鎖何總
2024門鎖網專訪凱理五金王總
2024門鎖網專訪三彪名派智能鎖黃總
隨著人工智能技術和物聯網技術的完善和普及,智能家居已經進入到千家萬戶,在消費升級背景下,智能門鎖已然成為智能家居市場的一大風口。
為了探尋飛利浦智能鎖的起步歷程和未來規劃,我們特地專訪了飛利浦銷售總監劉志丹先生,希望能夠找到飛利浦成功的奧義所在,為行業的良性發展帶來一些啟示和靈感。
中居聯杯·2024年度門鎖及智能鎖十大品牌獲獎名單
2024門業及定制家居品牌峰會暨中居聯杯·2023年度木門及門墻柜整裝十大品牌表彰盛典圓滿落幕
飛利浦智能鎖采用半導體指紋傳感器,識別靈敏度高,不僅能透過皮膚表皮層去采集更精細的指紋細節,還具備指紋認證修復功能。
隨著人們安全意識的不斷提高,家庭安防正在成為智能家居產品中日益崛起的一部分,其中涉及到的產品包括家用攝像機、智能門鎖、智能貓眼、智能門鈴、門磁傳感器、紅外報警器等等。據相關數據統計,家庭安防類設備在2...
CEEASIA亞洲三大專業消費電子展之一、一年一度的消費電子全產業鏈大會 —— CEEASIA亞洲消費電子展(北京)將于2022年6月25日-27日在中國北京亦創國際會展中心舉行。10月25日,中新展...
讓加盟更誠信 讓選擇更放心
立即咨詢做有權威的品牌